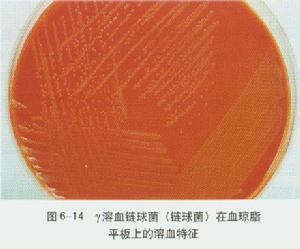
天蓝色链霉菌

红色链霉菌

导语:在20世纪40年代时,医学家把红链霉菌分离出红霉素,这是红霉素第1
图片尺寸1280x798
一,小雨90昨晚买了盒9191,因为是晚上,水果摊又用红色的灯照着
图片尺寸1080x1439
天蓝色链霉菌
图片尺寸300x249
2024年提高抗微生物药物认识周丨一天认识一种抗菌药之多西环素
图片尺寸847x1238
盐霉素是由白色链霉菌dsm 41398产生的一种离子载体抗生素,它能够妨碍
图片尺寸350x325
规格:99产品类别:抗病毒他克莫司(tacrolimus),又名fk506,是从链霉
图片尺寸700x700
来自于链霉菌streptomyces avicllrdi的亲和素.
图片尺寸592x438
5.砧板上的大肠杆菌和链霉菌会导致肠道外感染,急性腹泻,肝炎等.
图片尺寸600x402
是一种通过阿维链霉菌发酵产生的大环内酯抗生素类杀菌杀虫杀螨剂
图片尺寸1080x1439
20世纪40年代,科学家从红链霉菌分离出红霉素,这是红霉素第一次走近
图片尺寸750x500
好收成m6-国家专利vsf弗氏链霉菌菌剂-江苏好收成韦恩农化股份有限
图片尺寸1027x764
微生物菌剂:改良土壤 恢复地力的"救命稻草"!
图片尺寸550x390
一种那西肽粗品的制备方法技术
图片尺寸480x360